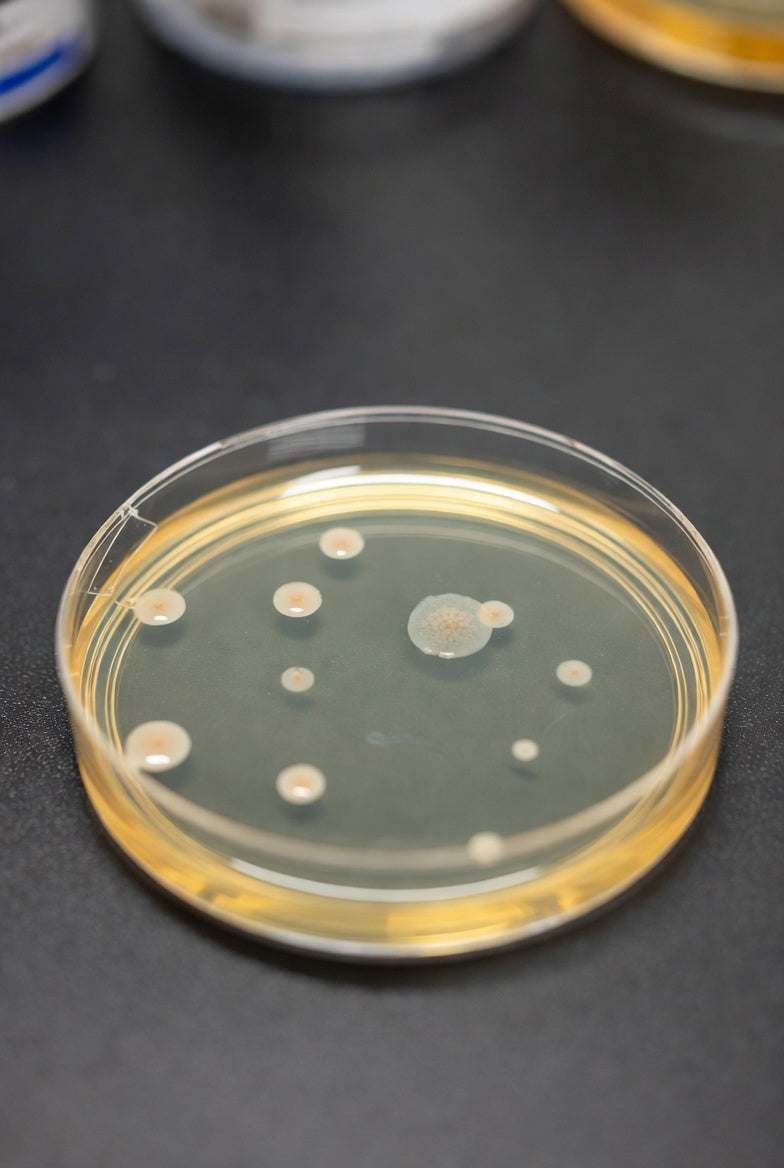
Image of Maximizing Lab Efficiency with Tryptone Soy Agar (TSA) Prepared Plates from Luminix Health - Luminix Health

Maximizing Lab Efficiency with Tryptone Soy Agar (TSA) Prepared Plates from Luminix Health
In the fast-paced world of microbiology and research, having reliable tools at your disposal is crucial for accurate results and...
Everything you need to know about regulatory frameworks and medtech logistics.
In the fast-paced world of microbiology and research, having reliable tools at your disposal is crucial for accurate results and...
Heading
Add address
Heading
Add address
Heading
Add address